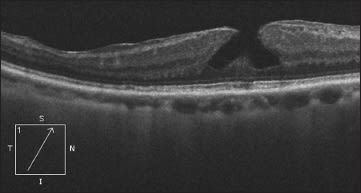

CONTROVERSIES IN CARE
Does Surgery for Lamellar Macular Holes Offer Distinct Gains?
EDITED BY Michael Colucciello, MD
Lamellar macular holes have been something of a curiosity ever since Gass first described the phenomenon in 1975, occurring in association with an “epiretinal membrane” in a patient with chronic postoperative CME following cataract surgery.1 These partial-thickness macular holes, in which the inner layers of the fovea are involved with traction and are detached from the underlying cellular layers of the fovea, appear on biomicroscopy as round, well-circumscribed reddish defects in the foveal region. They cause metamorphopsia and blurred vision.
Clinical detection of a lamellar macular hole can be difficult with conventional biomicroscopic techniques. With OCT, however, they are easily diagnosed: a break in the inner fovea but intact foveal photoreceptors, intraretinal split, and irregular foveal contour but absence of a full-thickness foveal defect are characteristic findings (Figure 1)2 Lateral intraretinal splits or clefts between the inner and outer retinal layers may be seen.3

Figure 1. Lamellar macular holes are easily diagnosed with OCT: a break in the inner fovea but intact foveal photoreceptors, intraretinal split and irregular foveal contour but absence of a full-thickness foveal defect are characteristic findings.
The pathophysiology of lamellar macular holes most probably involves an anomalous posterior vitreous separation with vitreous cortex contraction. The macular vitreous cortical contraction is induced by cytokine-mediated processes initiated by hyalocyte cytokine production.4, 5
| Michael Colucciello, MD, is a partner at South Jersey Eye Physicians and a clinical associate at the University of Pennsylvania/Scheie Eye Institute. He is a member of the Retina Society and the American Society of Retina Specialists. He has no financial disclosures to report. Gregg T. Kokame MD, MMM, is clinical professor of ophthalmology at the University of Hawaii School of Medicine, managing partner of Retina Consultants of Hawaii, and medical director of the hospital-based Retina Center at Pali Momi, HI. He reports no financial interest in any products mentioned in this article. Jay S. Duker, MD, is professor and chair of the New England Eye Center at the Tufts-New England Medical Center in Boston. He reports no financial interest in any products mentioned in this article. |
A persistently attached, contracting macular posterior vitreous cortex or contraction of the outer layer of vitreoschisis over the macula exerts a centripetal force on the fovea, resulting in a cleft between the inner and outer retina when the traction force exceeds the tensile strength of the attachment between the inner and outer retina.
Pars plana vitrectomy with ILM delamination (to be assured of removal of all vitreoschisis tissue, if present) and gas-fluid exchange may help restore anatomy — but are the visual results positive enough to recommend the procedure to patients?
In this edition of Controversies in Care, we are fortunate to have the viewpoints of Jay Duker, MD, professor and chair of ophthalmology at Tufts University School of Medicine, and Gregg T. Kokame, MD, MMM, clinical professor at the University of Hawaii School of Medicine, managing partner of Retina Consultants of Hawaii and medical director of the hospital-based Retina Center at Pali Momi, to help guide us.
REFERENCES
1. Gass JD. Lamellar macular hole: a complication of cystoid macular edema after cataract extraction: a clinicopathologic case report. Trans Am Ophthalmol Soc. 1975;73:230-250.
2. Witkin AJ, Ko TH, Fujimoto JG, et al. Redefining lamellar holes and the vitreomacular interface: an ultrahigh-resolution optical coherence tomography study. Ophthalmology. 2006; 113:388-397.
3. Chen JC, Lee LR. Clinical spectrum of lamellar macular defects including pseudoholes and pseudocysts defined by optical coherence tomography. Br J Ophthalmol. 2008;92:1342-1346.
4. Sebag J, Gupta P, Rosen RR, et al. Macular holes and macular pucker: the role of vitreoschisis as imaged by optical coherence tomography/scanning laser ophthalmoscopy. Trans Am Ophthalmol Soc. 2007; 105:121-131.
5. Parolini B, Schumann RG, Cereda MG, et al. Lamellar macular hole: a clinicopathologic correlation of surgically excised epiretinal membranes. Invest Ophthalmol Vis Sci. 2011; 52:9074-9083.
Surgery for Lamellar Macular Hole Can Make a Difference
Gregg T. Kokame, MD, MMM
Lamellar macular hole (LMH) can be approached surgically with improvement visually and anatomically in select cases. This approach was first evaluated in July 2005, when a patient presented with a lamellar macular hole and very symptomatic blurred vision and metamorphopsia. At the time, no known or published treatment for lamellar macular hole existed.
However, full-thickness macular hole (FTMH) had recently become surgically correctable after more than 100 years of being recognized but untreatable. In the late 1980s, J. Donald M. Gass, MD, had excited the retina community by defining the early stages of macular hole and identifying cortical vitreous traction as the cause of macular hole.1-2 Being with him as a retina fellow at the Bascom Palmer Eye Institute in that era was an exciting time.
Neil Kelly, MD, and Rob Wendel, MD, then first showed successful closure of FTMH after vitrectomy, membrane peeling, and fluid-gas exchange.3 Since then, FTMH surgery results have markedly improved. In addition, a remarkable plasticity of the fovea was noted, with recovery of a normal foveal contour in many cases.
Because of my patient's significant symptoms, a pars plana vitrectomy, peeling of epiretinal membrane and ILM, and air-fluid exchange was performed. The patient positioned face down for two days. The OCT results following surgery were impressive, demonstrating a smooth foveal depression and resolution of the LMH. Visual acuity improved from 20/60 to 20/30 with better visual function.4
These exciting results were presented at the Macula Society meeting in February 2006 and at the Cannes Retina Festival that summer. LMH surgery has now been investigated in further studies.5-8 The results have varied, but different authors define lamellar macular holes in different ways.
A true lamellar macular hole has a partial-thickness defect with surrounding overhanging borders over the floor of the LMH (Figure 2). Gaudric has also emphasized the presence of split foveal edges at the margin of the LMH on OCT.9 While ERM is often present, it is not a prominent part of LMH.
Figure 2. A true lamellar macular hole has a partial-thickness defect with surrounding overhanging borders over its floor.
Other authors have broadened the definition of LMH as any inner lamellar defect, including cases with vitreomacular traction syndrome and my opic retinoschisis.7 The prognosis of these cases, in my opinion, is more affected by the underlying diagnosis than by the presence of a true LMH.
In addition, there is overlap of: (1) macular pseudohole and ERM, which has steep borders on OCT; and (2) LMH, which has overhanging borders with split foveal edges on OCT.9,10 The case example above in the introduction is a good example, where one margin has a curved inner contour more consistent with a lamellar hole, and the other margin has a steep perpendicular contour and ERM characteristic of a macular pseudohole.
Excellent visual results similar to our case have been seen after LMH surgery. A large series of 27 eyes by the Royal Oaks group and Garretson and colleagues showed a 93% visual improvement rate with a mean improvement of 3.2 Snellen lines.6 OCT improvement was noted in 92% of cases. Hirakawa and colleagues from Kagoshima, Japan, also noted similar independent positive results after vitrectomy and intraocular gas for lamellar macular hole.5
With regard to tamponade following LMH surgery, authors have reported successful results without tamponade,6 with air4, 6 and with gas.5, 6-8 Recovery without tamponade can be seen even in FTMH, in which spontaneous macular hole closure is noted, and more recently when closure is noted after microplasmin use to create vitreous separation.
In my opinion, a higher percentage of recovery of foveal contour and architecture after LMH surgery would occur with intraocular tamponade. I still recommend air tamponade and two days of face-down positioning, but longer-acting gas is a reasonable surgeon choice.
While LMH surgery can be successful, many cases of LMH may remain stable with minimal symptoms for a long period of time.11 Many of these patients do not need and would not benefit from surgery. However, in patients with significant visual symptoms, there is no question that LMH is no longer untreatable and that surgery can allow for both anatomic and visual improvement.
REFERENCES
1. Gass JD. Idiopathic senile macular hole:its early stages and pathogenesis. Arch Ophthalmol. 1988; 106:629-639.
2. Johnson RN, Gass JD. Idiopathic macular holes. Observations, stages of formation, and implications for surgical intervention. Ophthalmology. 1988; 95:917-924.
3. Kelly NE, Wendel RT. Vitreous surgery for idiopathic macular holes. Results of a pilot study. Arch Ophthalmol. 1991; 109:654-659.
4. Kokame GT, Tokuhara KG. Surgical management of inner lamellar macular hole. Ophthalmic Surg Lasers Imaging. 2007; 38:61-63.
5.Hirakawa M, Uemura A, Nakano T, Sakamoto T. Pars plana vitrectomy with gas tamponade for lamellar macular holes. Am J Ophthalmol. 2005; 140:1154-1155.
6. Garretson BR, Pollack JS, Ruby AJ, Dresner KA, Williams GA, Sarrafizadeh R. Vitrectomy for a symptomatic lamellar macular hole. Ophthalmology. 2008; 115:884-886.
7. Witkin AJ, Castro LC, Reichel E, Rogers AH, Baumal CR, Duker JS. Ophthalmic Surg Lasers Imaging. 2010; 41:418-424.
8. Casparis H, Bovey EH. Surgical treatment of lamellar macular hole associated with epimacular membrane. Retina. 2011; 31:1783-1790.
9. Haouchine B, Massin P, Tadayoni R, Erginay A, Gaudric A. Diagnosis of macular pseudoholes and lamellar macular holes by optical coherence tomography. Am J Ophthalmol. 2004:138:732-739.
10. Michalewska Z, Micahelewski J, Odrobina D, Nawrocki J. Non-full-thickness macular holes reassessed with spectral domain optical coherence tomography. Retina. 2011 Sep 8 . [Epub ahead of print]
11. Smiddy WE, Gass JD. Masquerades of macular holes. Ophthalmic Surg. 1995; 26:16-24.
Cases of Lamellar Macular Hole Submitted to Surgery Should Be Carefully Chosen
Jay Duker, MD
Gass initially described lamellar macular hole resulting from the rupture of a foveal cyst in the setting of postcataract CME or, alternatively, as an aborted macular hole.1 Historically, they were described to be generally stable anatomically. Because early re ports suggested that lamellar macular holes resulted in only a modest reduction in visual acuity (20/25 to 20/40), in most cases, vitreous surgery was not usually considered.
More recently, OCT has expanded the definition of lamellar macular hole to include a host of other pathogenic causes, including ERM, posterior vitreous detachment with vitreoschisis, vitreomacular traction syndrome, myopic macular schisis and diabetic retinopathy.2
OCT can reveal unusually “thick” membranes in some lamellar holes that represent residual hyaloid on the inner retinal surface after apparent PVD (Figure 3). In addition, it is evident that lamellar macular holes can progress both anatomically and visually and can be the cause of significant visual dysfunction in some eyes.

Figure 3. A lamellar macular hole associated with “thick” epiretinal membrane due to residual hyaloid on the inner retinal surface (white arrows). This eye had a previous retinal detachment. Visual acuity was 20/80.
Several recent clinical studies suggest both anatomic and visual success can be achieved in symptomatic eyes with lamellar macular hole using vitrectomy with membrane peeling techniques (Figure 4).3-6 Such successes can be achieved with an acceptable complication rate.

Figure 4. A 53-year-old man with progressively decreasing vision to 20/60 in the right eye associated with ERM and lamellar hole (A). One year after PPV with ERM peel assisted with intraoperative triamcinolone (B). Despite mild persistent retinal thickening, the visual acuity was 20/25.
As in virtually all elective surgery, patient selection is critical to maximize anatomic and visual success, as well as patient satisfaction. Surgery should be limited to those eyes that are symptomatic and have documented decreased vision to a significant level and/or documented visual decline. Surgery for eyes with lamellar holes in the setting of myopic macular schisis should probably be reserved for severe central visual loss, as the success rate is lower, and the complication rate is higher.
A core vitrectomy with removal of the hyaloid from the macula and peeling of any membrane are critical for success of the surgery. The use of intravitreal triamcinolone as a surgical adjunct can be useful for identifying residual hyaloid. Some surgeons advocate peeling of the ILM in all cases to improve anatomic success and prevent recurrent ERM formation.
The use of intraoperative tamponade with air or gas, followed by some length of face-down positioning, remains controversial. While it carries little morbidity, without a full-thickness retinal defect, it is probably of limited benefit.6 RP
REFERENCES
1. Gass JD. Lamellar macular hole: a complication of cystoid macular edema after cataract extraction: a clinicopathologic case report. Trans Am Ophthalmol Soc. 1975; 73:230-250.
2. Witkin AJ, Ko TH, Fujimoto JG, et al. Redefining lamellar holes and the vitreomacular interface: an ultrahigh-resolution optical coherence tomography study. Ophthalmology. 2006; 113:388-397.
3. Kokame GT, Tokuhara KG. Surgical management of inner lamellar macular hole. Ophthalmic Surg Lasers Imaging. 2007; 38:61-63.
4. Garretson BR, Pollack JS, Ruby AJ, Drenser KA, Williams GA, Sarrafizadeh R. Vitrectomy for a symptomatic lamellar macular hole. Ophthalmology. 2008; 115:884-886.
5. Witkin AJ, Castro LC, Reichel E, Rogers AH, Baumal CR, Duker JS. Anatomic and visual outcomes of vitrectomy for lamellar macular holes. Ophthalmic Surg Lasers Imaging. 2010; 41:418-424.
6. Michalewska Z, Michalewski J, Odrobina D, et al. Surgical treatment of lamellar macular hole. Graefes Arch Clin Exp Ophthalmol. 2010; 248:1395-1400.








